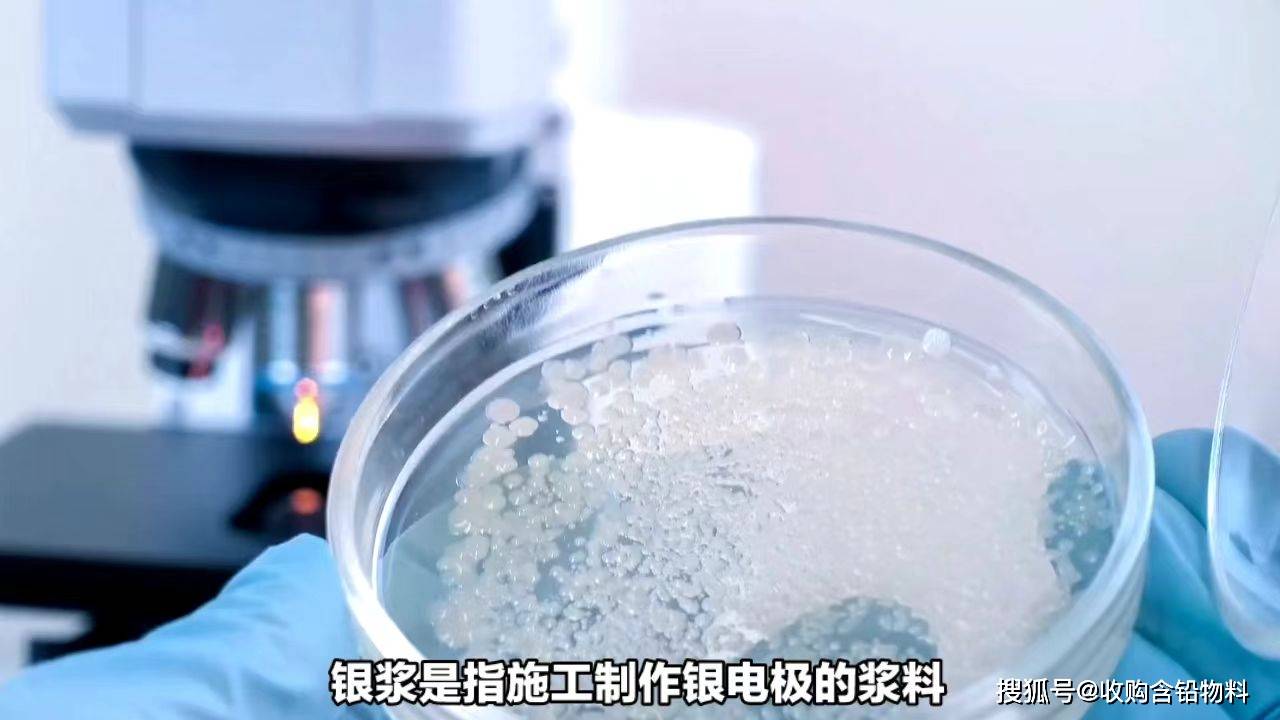

银浆是指施工制作银锭级的浆料,广泛应用于电子工业,可以说是电子工业的血液,在最新的技术上,既有纳米银浆,银浆有因或其他化合物助溶剂,粘合剂和稀剂配制而成,按银的存在形式,可分为氧化银浆,碳酸银浆,分子银浆,按烧银温度,可分为高温银浆和低温银浆,印刷银浆和喷涂银浆,目前仍将广泛应用在电子工业中,随着5G技术的日渐应用,与消费电子范围的不断提高,光伏行业不断扩大,而对银浆的需求越来越大,这些都间接推动了白银的价格,现在白银的价格也创下近年来最好的价格,盈江在电子工业中有着广泛的应用,以下是一些盈江长常见的用途,一,电极制造,银浆用于制造电子产品中的电极,如电容器,传感器,触摸屏等,它具有良好的导电性能和可塑性,能够提供稳定的电流传输和连接性,二,连接器应将常用于制造电子设备内部的连接器,如芯片封装,硬质电路板,电子焊接等,它可以提供可靠的连接和导电性能,确保设备的正常工作,三太阳能电池板,银浆被广泛应用于太阳能电池板的制造过程中,它用于制作太阳能电池板的前电极和背电极,起到提供电流和导电的作用,帮助转化太阳能为电能,四,光伏产业,盈江也在光伏产业中发挥重要作用,它用于制造光伏电池的电极,提供良好的导电性能和高效的能量转换效率,总之,银浆在电子工业中的应用非常广泛,它能够提供可靠的导电性能和连接性,帮助制造出更高效稳定和可靠的电子器件。
免责声明
本文仅代表作者观点,不代表本站立场,著作权归作者所有;作者投稿可能会经本站编辑修改或补充;本网站为服务于中国中小企业的公益性网站,部分文章来源于网络,百业信息网发布此文仅为传递信息,不代表百业信息网赞同其观点,不对内容真实性负责,仅供用户参考之用,不构成任何投资、使用建议。请读者自行核实真实性,以及可能存在的风险,任何后果均由读者自行承担。如广大用户朋友,发现稿件存在不实报道,欢迎读者反馈、纠正、举报问题;如有侵权,请反馈联系删除。(反馈入口)
本文链接:https://www.byxxw.com/zixun/32016.html- 上一篇: 百业兴旺什么意思
- 下一篇: 深圳市青少年心理咨询中心大家觉得可以信赖么?











